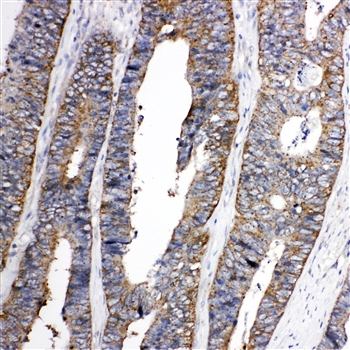
Eph receptor A1/EPHA1 Antibody

You have no items in your shopping cart.
Cart summary
Item 1 of 4
Item 1 of 4
EPHA1 Antibody
Catalog Number: orb45830
Product Properties
| Catalog Number | orb45830 |
|---|---|
| Category | Antibodies |
| Description | This EPHA1 Antibody is an unconjugated polyclonal product. It tagets EPHA1 using a Recombinant Human Ephrin type-A receptor 1 protein (296-414AA) as the immunogen. This antibody is suitable for ELISA, IF, IHC, WB. Purification: >95%, Protein G purified. |
| Target | EPHA1 |
| Clonality | Polyclonal |
| Species/Host | Rabbit |
| Isotype | IgG |
| Conjugation | Unconjugated |
| Reactivity | Human, Mouse |
| Form/Appearance | Liquid |
| Buffer/Preservatives | Preservative: 0.03% Proclin 300. Constituents: 50% Glycerol |
| Purification | >95%, Protein G purified |
| Immunogen | Recombinant Human Ephrin type-A receptor 1 protein (296-414AA) |
| UniProt ID | P21709 |
| Tested applications | ELISA, IF, IHC, WB |
| Dilution range | WB:1:1000-5000, IHC-P:1:20-200, IF:1:50-200 |
| Storage | Maintain refrigerated at 2-8°C for up to 2 weeks. For long term storage store at -20°C in small aliquots to prevent freeze-thaw cycles. |
| Alternative names | EPH antibody; EPH receptor A1 antibody; EPH tyrosi Read more... |
| Research Area | Cardiovascular Research |
| Note | For research use only |
| Expiration Date | 12 months from date of receipt. |
Images

Western blot analysis of Mouse brain tissue using EPHA1 antibody

Immunohistochemical staining of human gastric cancer using EPHA1 antibody

Immunofluorescence analysis of A549 cells using EPHA1 antibody

Immunohistochemical staining of human liver cancer using EPHA1 antibody
Similar Products
Human Ephrin Type A Receptor 1 (EPHA1) ELISA Kit [orb775763]
Human
0.32-20 ng/mL
0.121 ng/mL
48 T, 96 TEphA1 rabbit pAb [orb765145]
ELISA, IF, IHC-P, WB
Human, Mouse, Rat
Polyclonal
Unconjugated
100 μl, 50 μlEph receptor A1/EPHA1 Antibody [orb76087]
IHC, WB
Human, Mouse, Rat
Rabbit
Polyclonal
Unconjugated
100 μg
Reviews
EPHA1 Antibody (orb45830)
Based on 0 reviews
Participating in our Biorbyt product reviews program enables you to support fellow scientists by sharing your firsthand experience with our products.
Login to Submit a Review